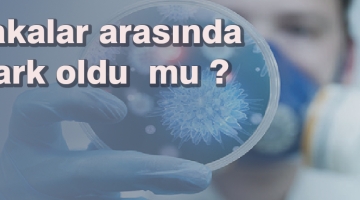

Şişli Belediyesi Bilgilendirme
Yetim Vakfı Kışın Yetim Çocukların Yanında

Koop Bakkal Açılıyor!

GoldUp ile Yatırımın Zirve Noktasını Yaşayın

Türk Diş Hekimleri, Uluslararası Kongrede Bir Arada

Sırp Çete Lideri Sarıyer'de Yakalandı!

Doğu Ekspresi Yolculukları Başlıyor!

Okullarda Yemek Verilmesini Meclis Tarafından Reddedildi!

TOGG'un Deposu 235 TL'ye Dolacak!

2023 Trafik Cezaları Ne Kadar Oldu?

Osmanlı Ve Cumhuriyet Tarihinde Önemli Rolleri Bulunan 40 Kadının Özel Arşivi “40 Kadın 40 Hayat” Kitabı İle Okurlarla Buluşuyor

Sadun Boro, 94’üncü Doğum Gününde Anıldı

Şişli Belediyesi Avrupa Yönetişim Mükelmelliği Markası'nı Aldı

Armağan Çağlayan'dan Mustafa Destici'ye Asgari Ücret Tepkisi! Gündem Oldu!

Rasim Ozan Kütahyalı İlk Defa Buket Aydın'a Açıkladı!

Öğretmenler İşi Mi Bırakıyor?

Elon Musk Twitter'da Yaptığı Değişikliklerle Yine Gündemde! Bu Sefer Konu Mavi Tik!

gazete köşe yazısı yazmak pr yaptırmak haber yaptırmak istiyorum